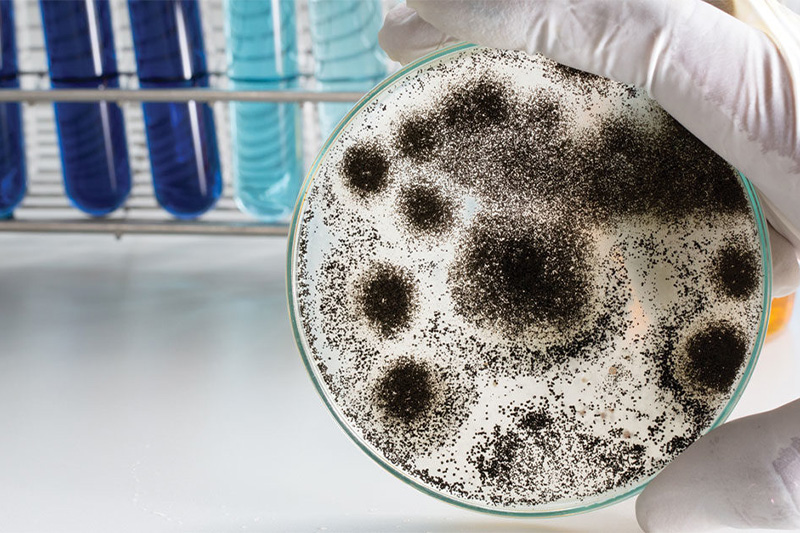

Understanding Mold Illness Class Added to Medical School’s Curriculum
Aug. 1 through Nov. 1, George Washington School of Medicine & Health Sciences will offer Understanding Mold Illness: The Basics. The course is designed to teach the medical basics of mold-related illness to ancillary providers and industry professionals.
While mold exposure is well known to cause allergic responses and pulmonary disease, less well recognized is the inflammatory response it generates in vulnerable individuals. During the past decade, research studies have uncovered the systemic reactions to mold and mycotoxins, and the resultant multi-symptom, multi-system illness that arises.
The medical school’s course is designed to cover the fundamental mechanisms by which this illness arises and to offer a framework for ancillary providers and industry professionals to communicate effectively with this clinical population.
While the course is targeted to the healthcare industry, all participants will learn how to:
- Review the epidemiology of mold-related illness.
- Identify common complaints and symptoms.
- Understand the basic pathophysiology of how mycotoxin exposure initiates an inflammatory response.
- Synthesize common assessments and treatments.
- Build a framework to communicate effectively with individuals affected by water-damaged buildings and mold exposure.
The course falls under the umbrella of the National Organization of Remediators and Microbial Inspectors (NORMI™) Medical Advisory Board and the Level Four Protocol and the NORMI Certified Remediation for Sensitized Individuals (NCRSI) credential. It will be taught by leading environmental health expert Dr. Andrew Heyman, MD, who also chairs the NORMI Medical Advisory Board. This initiative represents a major milestone in aligning remediation practices with medical science giving indoor air quality (IAQ) professionals, mold remediators, and water damage restoration specialists the tools to deliver safer, more effective outcomes for clients affected by mold-related illness.
Related Posts












